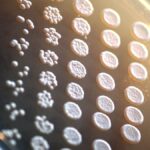

ITBP SI (Hindi Translator) Recruitment 2024: Overview and Important Information
The Indo-Tibetan Border Police Force (ITBP) has released a vacancy increase notice for the recruitment of Sub-Inspector (SI) posts. The total number of posts for ITBP SI (Hindi Translator) Recruitment 2024 is 27. The notice was released on 10 May 2025. Here’s all the important information and links for the recruitment:
Overview
- Recruitment Organization: Indo-Tibetan Border Police Force
- Post Name: Sub Inspector
- Vacancies: 27
- Job Location: All India
- Category: ITBP SI (Hindi Translator) Recruitment 2024
- Official Website: recruitmentt.itbpolice.nic.in
Important Dates
- Apply Start Date: 28 July 2024
- Apply Last Date: 26 August 2024
- Exam Date: To be notified later
Application Fees
- Gen/OBC/EWS: Rs. 200
- SC/ST/PWD: Rs. 0
- Mode of Payment: Online
Age Limit
- The age limit for this recruitment is 18-30 years. The crucial date for the calculation of the age limit is 26.8.24. Age relaxation will be given as per the rules.
Vacancy Details and Qualification
- Post Name: Sub Inspector (Hindi Translator)
- Vacancy: 27 (17+ 10)
- Qualification: Check the notification for details
Selection Process
- Documents Verification
- Physical Test
- Written Exam
- Medical Examination
Important Links
- Vacancies Increase Notice: Download Notice
- ITBP SI (Hindi Translator) Recruitment 2024 Notification PDF: Download Notification
- Apply Online: Apply Form
- ITBP Official Website: ITBP
This recruitment is an opportunity for individuals to join the ITBP and contribute to border security. Make sure to apply before the last date to secure your spot.

![Nainital Bank Launches Recruitment 2025 - Apply Online for 100 Vacancies [Total Posts] Area: Banking & Finance](https://theprimenewsnetwork.com/wp-content/uploads/2025/05/Nainital-Bank-Launches-Recruitment-2025-Apply-Online-for-100-420x280.png)
